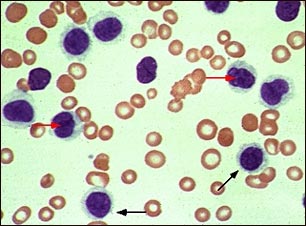

Médico-científicos en el Programa de Cáncer de la princesa Margarita han encontrado un enfoque prometedor para el tratamiento de la leucemia, el uso de un fármaco de edad de una manera nueva.
La investigación de prueba de concepto se publica hoy en Cancer Cell describe cómo el equipo canadiense descubrió que los objetivos de la tigeciclina con antibióticos y destruye las células de leucemia madre cortando la producción de energía de la célula.
«Si usted piensa en todas las células en el cuerpo como una red de energía, hemos descubierto que la tigeciclina puede causar un corte de energía en las células madre de la leucemia, al mismo tiempo mantener las luces encendidas en todas las células sanas», dice el Dr. Aaron Schimmer , el médico-científico de la familia Campbell Instituto de Investigación del Cáncer en el Programa de Cáncer de la princesa Margarita, la Red Salud de la Universidad. También es profesor asociado en los departamentos de medicina, biofísica médica, y el Instituto de Ciencias Médicas de la Universidad de Toronto (U de T).
Para identificar los medicamentos que se sabe con la capacidad no reconocido previamente para eliminar las células leucémicas y células de la leucemia madre, el equipo científico acumulado una librería de cientos de fármacos conocidos para tratar, incluyendo tigeciclina – un antibiótico por vía intravenosa que normalmente se usa para tratar infecciones de la piel y dolor abdominal. A alta velocidad, una pipeta de manejo de robots a prueba diferentes dosis de cada medicamento para ver si las células leucémicas afectados.
«La tecnología hizo posible este descubrimiento. En tres días, se encontró que los medicamentos potenciales la leucemia podría estar ocultando a la vista», dice el Dr. Schimmer. «Buscando a través de todas las combinaciones con la mano habría tomado meses.»
«Hemos probado más de 500 medicamentos existentes en la leucemia. De los pocos que tuvo un impacto, la tigeciclina fue el más potente de nuevos conocimientos y puso de manifiesto en la biología de la leucemia a nivel celular», dice el autor principal, Marko Skrtic, un MD / PhD estudiante de la Facultad de Medicina de la Universidad de Toronto, completando sus estudios de doctorado en el laboratorio del Dr. Schimmer es.
El equipo canadiense demostró que las células leucémicas tienen requisitos únicos de la energía y se puede cerrar de forma selectiva por esta producción de energía en las células de leucemia mediante el bloqueo de la síntesis de proteínas en la mitocondria.
Mediante la búsqueda de nuevos tratamientos en los medicamentos aprobados, los investigadores del cáncer puede ser capaz de analizar rápidamente estas nuevas estrategias en los pacientes, dice el Dr. Schimmer, que ahora está comenzando múltiples ensayos clínicos con tigeciclina en el tratamiento de la leucemia.






